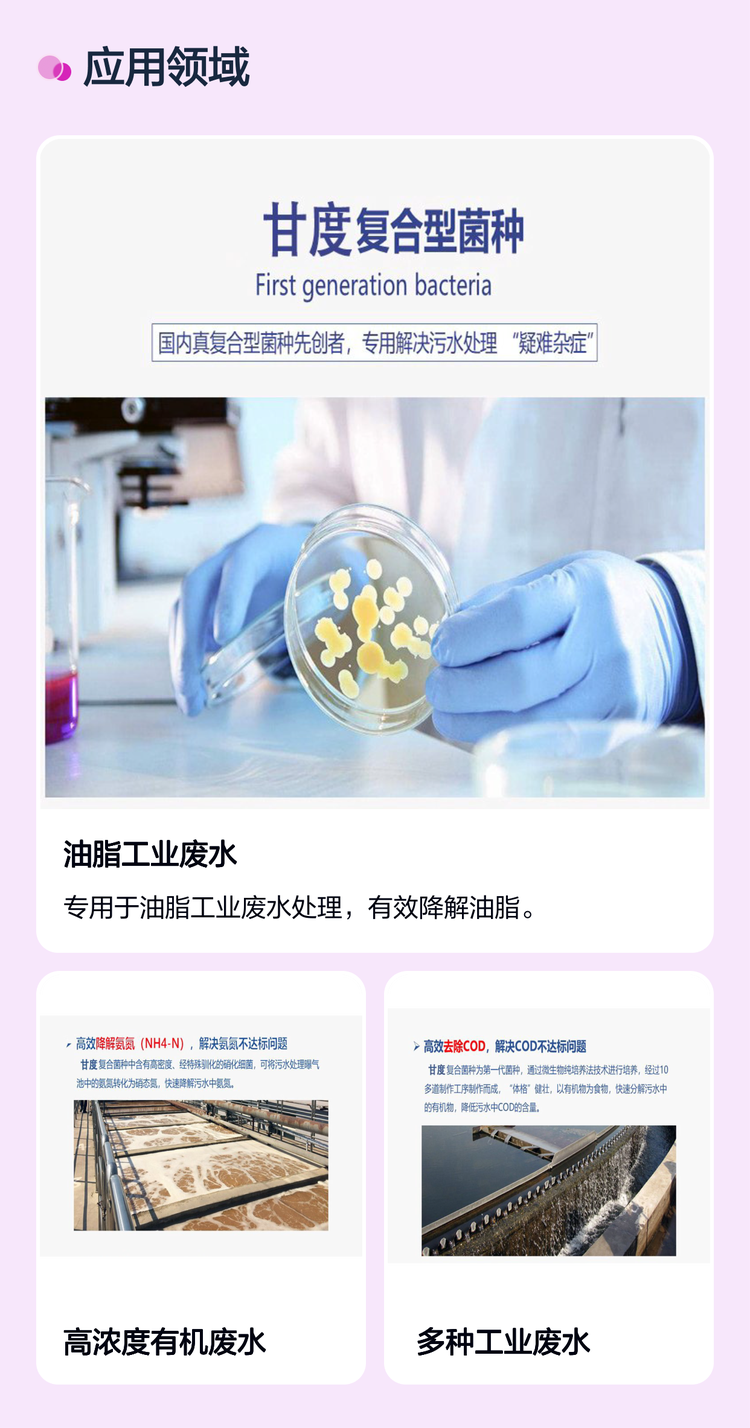

.jpg)
商铺名称:上海甘度环境工程有限公司
联系人:龙(先生)
联系手机:
固定电话:
企业邮箱:932859297@qq.com
联系地址:上海市奉贤区南桥镇宏伟路24号5幢9507室
邮编:5962713
联系我时,请说是在瑞启化工网上看到的,谢谢!
商品详情
| 产品参数 | |||
|---|---|---|---|
| 品牌 | 甘度 | ||
| 产品规格 | 1kg装 | ||
| PH值 | 6~9 | ||
| 外观性状 | 粉末 | ||
| 有效成分含量 | 98 | ||
| 执行标准 | 企标 | ||
| 是否进口 | 否 | ||
| 包装规格 | 1kg | ||
| 单件净重(g) | 1000 | ||
| 可否定制 | 可以 | ||
| 适用星级 | 所有星级 | ||
| 保质期 | 48个月 | ||
| 主要作用 | 降解氨氮COD总氮 | ||
| 名称 | 油脂分解菌 | ||
| 可售卖地 | 全国 | ||
| 型号 | GANDEW-MIX | ||
.jpg)
.jpg)
.jpg)
.jpg)
.jpg)
.jpg)
.jpg)
.jpg)
.jpg)
.jpg)
.jpg)
.jpg)
.jpg)
.jpg)
.jpg)
.jpg)
.jpg)
.jpg)
.jpg)